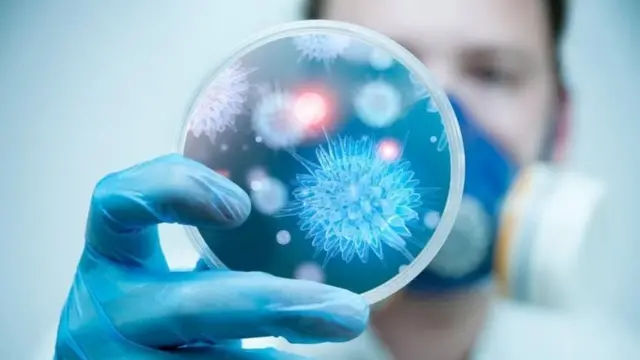
కరోనా

టి20 వరల్డ్ కప్ సూపర్ 12: గ్రూప్ 2లో టాప్ పొజిషన్లో పాకిస్తాన్ - BBC Newsreel

ఫొటో సోర్స్, Alex Davidson/getty images
టీ20 వరల్డ్ కప్ సూపర్ 12 గ్రూప్-2 మ్యాచ్లో పాకిస్తాన్ వరసగా రెండో విజయం అందుకుంది. రెండు విజయాలు, నాలుగు పాయింట్లతో గ్రూప్ 2లో పాకిస్తాన్ మొదటి స్థానంలో ఉంది.
న్యూజీలాండ్తో మంగళవారం పోటాపోటీగా జరిగిన మ్యాచ్లో 5 వికెట్ల తేడాతో పాకిస్తాన్ గెలిచింది.
భారత్తో రికార్డ్ భాగస్వామ్యం అందించిన ఓపెనర్లను కివీస్ బౌలర్లు త్వరగానే విడగొట్టినా.. వరసగా వికెట్లు పడుతూనే వచ్చినా.. చివరి వరుస బ్యాట్స్మెన్ జట్టుకు మరో విజయాన్ని అందించారు.
ముఖ్యంగా టిమ్ సౌథీ వేసిన 17వ ఓవర్ మ్యాచ్ ఫలితాన్నే మార్చేసింది. అప్పటివరకూ రెండు జట్లతో దోబూచులాడిన విజయం.. చివరికి పాకిస్తాన్నే వరించింది.
87 పరుగులకు ఐదు వికెట్లు కోల్పోయిన దశలో క్రీజులోకి వచ్చిన ఆసిఫ్ అలీ, పాక్ మాజీ కెప్టెన్ షోయబ్ మలిక్తో కలిసి మ్యాచ్ ఫలితాన్నే మార్చేశాడు..
ఈ కథనంలో X అందించిన సమాచారం కూడా ఉంది. వారు కుకీలు, ఇతర టెక్నాలజీలను ఉపయోగిస్తుండొచ్చు, అందుకే సమాచారం లోడ్ అయ్యే ముందే మేం మీ అనుమతి అడుగుతాం. మీరు మీ అనుమతి ఇచ్చేముందు X కుకీ పాలసీని , ప్రైవసీ పాలసీని చదవొచ్చు. ఈ సమాచారం చూడాలనుకుంటే ‘ఆమోదించు, కొనసాగించు’ను ఎంచుకోండి.
పోస్ట్ of X ముగిసింది, 1
షోయబ్ మలిక్ 20 బంతుల్లో 26, ఆసిఫ్ అలీ 12 బంతుల్లో 27 పరుగులు చేసి నాటౌట్గా నిలిచారు.
135 పరుగుల స్వల్ప విజయలక్ష్యంతో బరిలోకి దిగిన పాకిస్తాన్ గెలుస్తుందని 16వ ఓవర్ వరకూ ఎవరూ ఊహించలేదు.
కానీ 17వ ఓవర్లో ఆసిఫ్ అలీ కొట్టిన వరస సిక్సర్లు ఫలితాన్ని తారుమారు చేశాయి. ఇంకా 8 బంతులు మిగిలుండగానే 5 వికెట్ల తేడాతో విజయం అందుకునేలా చేశాయి.
ఓపెనర్, కెప్టెన్ బాబర్ ఆజమ్ (9) త్వరగానే అవుటైనా మరో ఓపెనర్ మొహమ్మద్ రిజ్వాన్ మిగతా బ్యాట్స్మెన్తో కలిసి స్కోరును ముందుకు తీసుకెళ్లడానికి ప్రయత్నించాడు.
కానీ, ఫకార్ జమాన్ (11), మొహమ్మద్ హఫీజ్ (11) తక్కువ పరుగులకే అవుటయ్యారు.
ఈ కథనంలో X అందించిన సమాచారం కూడా ఉంది. వారు కుకీలు, ఇతర టెక్నాలజీలను ఉపయోగిస్తుండొచ్చు, అందుకే సమాచారం లోడ్ అయ్యే ముందే మేం మీ అనుమతి అడుగుతాం. మీరు మీ అనుమతి ఇచ్చేముందు X కుకీ పాలసీని , ప్రైవసీ పాలసీని చదవొచ్చు. ఈ సమాచారం చూడాలనుకుంటే ‘ఆమోదించు, కొనసాగించు’ను ఎంచుకోండి.
పోస్ట్ of X ముగిసింది, 2
ప్రమాదకరంగా అనిపించిన మొహమ్మద్ హఫీజ్, మిచెల్ శాంట్నర్ బౌలింగ్లో ఇచ్చిన క్యాచ్ను బౌండరీ లైన్ దగ్గర డెవాన్ కాన్వే అద్భుతంగా డైవ్ చేసి అందుకున్నాడు.
తర్వాత 12వ ఓవర్లో ఓపెనర్ మొహమ్మద్ రిజ్వాన్ కూడా అవుటవడంతో పాకిస్తాన్ అభిమానులు షాక్ అయ్యారు.
రిజ్వాన్ 34 బంతుల్లో 33 పరుగులు చేసి సోధీ బౌలింగ్లో ఎల్బీగా వెనుదిరిగాడు.
తర్వాత 11పరుగులు చేసిన ఇమాద్ వసీమ్ కూడా 15వ ఓవర్లో ఎల్బీడబ్ల్యూ కావడంతో పాకిస్తాన్ కష్టాల్లో పడినట్టు అనిపించింది.
కానీ అదే ఓవర్లో వచ్చీ రాగానే ఫోర్ కొట్టిన అసిఫ్ అలీ పాకిస్తాన్కు విజయం ఆశలు రేపాడు. 15వ ఓవర్ ముగిసే సరికి పాకిస్తాన్కు విజయానికి 30 బంతుల్లో 44 పరుగులు కావాలి.
అప్పటికే ఆచితూచి ఆడుతున్న షోయబ్ మలిక్తో కలిసి ఆసిఫ్ స్కోరును ముందుకు నడిపాడు. 16వ ఓవర్లో షోయబ్ మలిక్ ఫోర్ బాదడంతో మొత్తం 7 పరుగులు వచ్చాయి. అప్పటికి పాక్కు 24 బంతుల్లో 37 పరుగులు కావాలి.
తర్వాత టిమ్ సౌథీ వేసిన ఓవర్ మ్యాచ్ స్వరూపాన్నే మార్చేసింది. మొదటి బంతికి ఒక షోయబ్ ఒక పరుగు తీయగానే క్రీజులోకి వచ్చిన ఆసిఫ్ అలీ వరసగా రెండు సిక్సర్లు కొట్టాడు.
18వ ఓవర్లో షోయబ్ మలిక్ ఒక ఫోర్తో పాటు సిక్సర్ బాదడంతో పాక్ విజయసమీకరణం 12 బంతుల్లో 9 పరుగులుగా మారింది.
19వ ఓవర్లో ఒక సిక్స్ కొట్టిన ఆసిఫ్ అలీ, తర్వాత మరో రెండు పరుగులు చేసి జట్టుకు విజయం అందించాడు.
135 పరుగులు చిన్న లక్ష్యమే అయినా ఆరంభంలో కివీస్ బౌలర్లు కట్టుదిట్టంగా బౌలింగ్ చేయడంతో పాక్ బ్యాట్స్మెన్లకు పరుగులు రాబట్టడం కష్టమైంది.
న్యూజీలాండ్ బౌలర్లలో ఇష్ సోధీ 2 వికెట్లు పడగొట్టగా... ట్రెంట్ బౌల్ట్, టిమ్ సౌథీ, మిచెల్ శాంట్నర్ తలో వికెట్ తీశారు.
ఈ కథనంలో X అందించిన సమాచారం కూడా ఉంది. వారు కుకీలు, ఇతర టెక్నాలజీలను ఉపయోగిస్తుండొచ్చు, అందుకే సమాచారం లోడ్ అయ్యే ముందే మేం మీ అనుమతి అడుగుతాం. మీరు మీ అనుమతి ఇచ్చేముందు X కుకీ పాలసీని , ప్రైవసీ పాలసీని చదవొచ్చు. ఈ సమాచారం చూడాలనుకుంటే ‘ఆమోదించు, కొనసాగించు’ను ఎంచుకోండి.
పోస్ట్ of X ముగిసింది, 3
న్యూజీలాండ్ బ్యాటింగ్
అంతకుముందు టాస్ ఓడి బ్యాటింగ్కు దిగిన న్యూజీలాండ్ ఆరో ఓవర్లో ఓపెనర్ మార్టిన్ గప్టిల్ (17) వికెట్ కోల్పోయింది.
డరైల్ మిచెల్ (27), జేమ్స్ నీషమ్ (1) వెంటవెంటనే అవుటవడంతో కెప్టెన్ కేన్ విలియమ్సన్, డెవన్ కాన్వే (27; 3 ఫోర్లు)తో కలిసి స్కోరు పెంచడానికి ప్రయత్నించాడు.
హసన్ అలీ బౌలింగ్లో పరుగుకు ప్రయత్నించిన విలియమ్సన్ (25; 2 ఫోర్లు, 1 సిక్స్) అతడి డైరెక్ట్ త్రోకు రనౌట్ అయ్యాడు.
ఈ కథనంలో X అందించిన సమాచారం కూడా ఉంది. వారు కుకీలు, ఇతర టెక్నాలజీలను ఉపయోగిస్తుండొచ్చు, అందుకే సమాచారం లోడ్ అయ్యే ముందే మేం మీ అనుమతి అడుగుతాం. మీరు మీ అనుమతి ఇచ్చేముందు X కుకీ పాలసీని , ప్రైవసీ పాలసీని చదవొచ్చు. ఈ సమాచారం చూడాలనుకుంటే ‘ఆమోదించు, కొనసాగించు’ను ఎంచుకోండి.
పోస్ట్ of X ముగిసింది, 4
తర్వాత హారిస్ రౌఫ్ తన 18వ ఓవర్లో వెంటవెంటనే కాన్వే, గ్లెన్ ఫిలిప్స్ (13) వికెట్లు తీయడంతో కివీస్ పరుగుల వేగం తగ్గిపోయింది.
ఇన్నింగ్స్ తొలి వికెట్ పడగొట్టిన హారిస్ రౌఫ్ మధ్యలో వరుస వికెట్లు తీయడంతోపాటూ 20వ ఓవర్ చివరి బంతికి శాంట్నర్ (6) ను కూడా ఔట్ చేశాడు.
దీంతో న్యూజీలాండ్ 20 ఓవర్లు ముగిసేసరికి 8 వికెట్ల నష్టానికి 134 పరుగులే చేయగలిగింది.
హారిస్ రౌఫ్ మొత్తం 22 పరుగులిచ్చి 4 వికెట్లు పడగొట్టగా, షాహీన్ అఫ్రిది, ఇమాద్ వసీమ్, మొహమ్మద్ హఫీజ్ తలో వికెట్ తీశారు.

ఫొటో సోర్స్, Francois Nel/getty images
వెస్టిండీస్పై 8 వికెట్ల తేడాతో దక్షిణాఫ్రికా విజయం
టీ20 వరల్డ్ కప్ సూపర్ 12లో భాగంగా మంగళవారం (అక్టోబర్ 26) జరిగిన మ్యాచ్లో వెస్టిండీస్పై దక్షిణాఫ్రికా 8 వికెట్ల తేడాతో విజయం సాధించింది.
ఈ కథనంలో X అందించిన సమాచారం కూడా ఉంది. వారు కుకీలు, ఇతర టెక్నాలజీలను ఉపయోగిస్తుండొచ్చు, అందుకే సమాచారం లోడ్ అయ్యే ముందే మేం మీ అనుమతి అడుగుతాం. మీరు మీ అనుమతి ఇచ్చేముందు X కుకీ పాలసీని , ప్రైవసీ పాలసీని చదవొచ్చు. ఈ సమాచారం చూడాలనుకుంటే ‘ఆమోదించు, కొనసాగించు’ను ఎంచుకోండి.
పోస్ట్ of X ముగిసింది, 5
ఆస్ట్రేలియాతో జరిగిన మొదటి మ్యాచ్లో 40 పరుగులు చేసిన ఎయిడెన్ మార్క్రామ్ వెస్టిండీస్పై కూడా చెలరేగిపోయాడు. 26 బంతుల్లో 4 సిక్సులు, 2 ఫోర్లతో 51 పరుగులు చేసి నాటౌట్గా నిలిచాడు.
మరోవైపు ధాటిగా ఆడిన రస్సీ వాన్ డర్ డసెన్ కూడా 51 బంతుల్లో 43 పరుగులు చేసి నాటౌట్గా నిలిచాడు. డసెన్ 3 బౌండరీలు బాదాడు.
ఓపెనర్, కెప్టెన్ టెంబా బవుమా(2) మరోసారి తక్కువ పరుగులకే అవుట్ కాగా, మరో ఓపెనర్ రీజా హెండ్రింక్స్ 30 బంతుల్లో 39 పరుగులు చేసి అవుట్ అయ్యాడు.
మూడో వికెట్కు అజేయంగా 83 పరుగులు భాగస్వామ్యం నెలకొల్పిన మార్క్రామ్, డసెన్ జోడీ దక్షిణాఫ్రికాకు విజయం అందించింది.
వెస్టిండీస్ బౌలర్లలో అకీల్ హుసేన్కు మాత్రమే ఒక వికెట్ పడింది.
ఈ కథనంలో X అందించిన సమాచారం కూడా ఉంది. వారు కుకీలు, ఇతర టెక్నాలజీలను ఉపయోగిస్తుండొచ్చు, అందుకే సమాచారం లోడ్ అయ్యే ముందే మేం మీ అనుమతి అడుగుతాం. మీరు మీ అనుమతి ఇచ్చేముందు X కుకీ పాలసీని , ప్రైవసీ పాలసీని చదవొచ్చు. ఈ సమాచారం చూడాలనుకుంటే ‘ఆమోదించు, కొనసాగించు’ను ఎంచుకోండి.
పోస్ట్ of X ముగిసింది, 6
వెస్టిండీస్ బ్యాటింగ్..
టాస్ ఓడి మొదట బ్యాటింగ్ చేసిన వెస్టిండీస్ మొదటి నుంచీ దూకుడుగా ఆడింది.
ముఖ్యంగా ఓపెనర్ ఎవిన్ లూయిస్ చెలరేగిపోయాడు. నాలుగో ఓవర్లో వరుసగా ఒక ఫోర్, సిక్స్ కొట్టిన లూయిస్.. ఐదో ఓవర్ చివరి మూడు బంతులకు వరుసగా రెండు సిక్సులు, ఒక ఫోర్ కొట్టాడు.
ఈ కథనంలో X అందించిన సమాచారం కూడా ఉంది. వారు కుకీలు, ఇతర టెక్నాలజీలను ఉపయోగిస్తుండొచ్చు, అందుకే సమాచారం లోడ్ అయ్యే ముందే మేం మీ అనుమతి అడుగుతాం. మీరు మీ అనుమతి ఇచ్చేముందు X కుకీ పాలసీని , ప్రైవసీ పాలసీని చదవొచ్చు. ఈ సమాచారం చూడాలనుకుంటే ‘ఆమోదించు, కొనసాగించు’ను ఎంచుకోండి.
పోస్ట్ of X ముగిసింది, 7
లూయిస్ 35 బంతుల్లో 3 ఫోర్లు, 6 సిక్సర్లతో 56 పరుగులు చేశాడు. కేశవ్ మహరాజ్ బౌలింగ్లో భారీ షాట్కు ప్రయత్నించి జట్టు స్కోరు 73 పరుగుల వద్ద తొలి వికెట్గా అవుటయ్యాడు.
నికోలస్ పూరన్ (12), క్రిస్ గేల్ (12) విఫలమయ్యారు.
తర్వాత వచ్చిన బ్యాట్స్మెన్లో కెప్టెన్ కీరన్ పొలార్డ్ (20 బంతుల్లో 26; 2 ఫోర్లు, 1 సిక్స్) మినహా ఎవరూ రెండంకెల స్కోరు చేయలేకపోయారు.
20 ఓవర్ మొదటి బంతికి పొల్లార్డ్ కొట్టిన బంతి అంపైర్ మీదుగా వెళ్లి దక్షిణాఫ్రికా ఫీల్డర్ డసెన్ చేతిలో పడింది. బంతి నేలకు తగిలిందా, లేదా అనేది అర్థం కాకపోవడంతో ఫీల్డ్ అంపైర్లు థర్డ్ అంపైర్ సాయం కోరారు.
చాలాసార్లు ఆ బంతిని పరిశీలించిన అంపైర్లు చివరికి పొలార్డ్ అవుటైనట్లు ప్రకటించారు. దీంతో వెస్టిండీస్ నిర్ణీత 20 ఓవర్లలో 8 వికెట్ల నష్టానికి 143 పరుగులే చేయగలిగింది.
దక్షిణాఫ్రికా బౌలర్లలో డ్వేన్ ప్రిటోరియస్కు 3, కేశవ్ మహరాజ్కు 2, కగిసో రబడ, అన్రిచ్ నోర్జేలకు ఒక్కో వికెట్ దక్కాయి.
ఫొటో సోర్స్, Getty Images
చైనాలో మళ్లీ పెరుగుతున్న కోవిడ్ కేసులు
చైనాలో మళ్లీ కరోనావైరస్ కేసులు పెరుగుతున్నాయి. తాజాగా 11 ప్రావిన్సుల్లో 133కు పైగా కోవిడ్ కేసులు బయటపడ్డాయి. అన్నీ కూడా ప్రమాదకరమైన డెల్టా వేరియంట్ ఇన్ఫెక్షన్లే.
మళ్లీ కోవిడ్ విజృంభించే అవకాశం ఉందని చైనా ఆరోగ్య శాఖ అధికారులు హెచ్చరించారు.
ఈ ఏడాది ఆగస్టులో నాన్జింగ్లో కరోనావైరస్ వ్యాప్తి ఆందోళన కలిగించింది.
ఆ తరువాత చైనాలో ఇంత పెద్ద సంఖ్యలో కోవిడ్ కేసులు నమోదు కావడం ఇదే మొదటిసారి.
దాంతో కరోనావైరస్ను అదుపుచేయడంలో చైనా సామర్థ్యంపై సందేహాలు వ్యక్తం అవుతున్నాయి.

ఫొటో సోర్స్, GETTY IMAGES
మరోవైపు, కరోనా కేసులు పెరుగుతుండటంతో బీజింగ్ మారథాన్ను నిరవధికంగా వాయిదా వేశారు.
1981 నుంచి నిర్వహిస్తున్న బీజింగ్ మారథాన్, చైనాలో జరుపుకునే అతి పెద్ద క్రీడోత్సవాలలో ఒకటి.
అక్టోబర్ 31న జరగాల్సి ఉన్న ఈ మారథాన్లో దాదాపు 30,000 మంది పాల్గొంటారని అంచనా.
"కోవిడ్ వ్యాప్తికి అవకాశం ఉందని భావిస్తూ.. రన్నర్స్, సిబ్బంది, స్థానికుల ఆరోగ్యం, భద్రత దృష్ట్యా ఈ మారథాన్ను రద్దు చేస్తున్నట్లు" నిర్వాహకులు ప్రకటించారు.
2022 వింటర్ ఒలింపిక్స్కు కూడా చైనా ఆతిధ్యం ఇవ్వనుంది. ఈ నేపథ్యంలో చైనా జీరో-కోవిడ్ విధానం అమలుపై అనుమానాలు తలెత్తుతున్నాయి.
తాజా కోవిడ్ వ్యాప్తి నియంత్రణకు చైనా ప్రయాణాలపై ఆంక్షలు విధించింది. టెస్టుల సంఖ్యను పెంచింది. ప్రజలు కూడా అప్రమత్తంగా ఉండాలని విజ్ఞప్తి చేసింది.
కోవిడ్ ప్రభావిత ప్రాంతాలలో పర్యటనలపై నిషేధం విధించింది.
ఆస్ట్రేలియా లాంటి దేశాలు జీరో-కోవిడ్ విధానం నుంచి పక్కకు తప్పుకుని వైరస్తో కలిసి జీవించే విధానానికి మారాయి.
కానీ చైనా, జీరో-కోవిడ్ వ్యూహానికే కట్టుబడి ఉంది. కఠినమైన లాక్డౌన్లు, అధిక సంఖ్యలో టెస్టులు, భారీ స్థాయిలో వ్యాక్సినేషన్ విధానాలను అమలుచేస్తోంది.
గత శనివారానికి ఆ దేశ జనాభాలో 75.6 శాతానికి రెండు డోసుల వ్యాక్సీన్ వేశారు.
ఇవి కూడా చదవండి:
- డెల్టా ప్లస్ కరోనా వేరియంట్: ఇట్టే వ్యాపిస్తుంది... ఇప్పుడున్న వ్యాక్సీన్లకు లొంగుతుందా?
- టీ20 వరల్డ్ కప్ సూపర్ 12: బంగ్లాదేశ్పై 5 వికెట్ల తేడాతో శ్రీలంక విజయం
- Ivermectin: కోవిడ్-19పై ఈ ఔషధం అద్భుతంగా పోరాడుతోందా? ఈ వార్తల్లో నిజమెంత
- బంగ్లాదేశ్లో హిందువులపై దాడుల విషయంలో భారత్ ఎందుకు ఆచితూచి వ్యహరిస్తోంది
- కరోనా సైడ్ ఎఫెక్ట్స్: కాలి వేళ్ల మీద పుండ్లు ఎందుకు ఏర్పడుతున్నాయి?
- సెక్స్ ట్రేడ్ కోసం యూరప్కు మహిళల అక్రమ రవాణా... తప్పించుకున్న ఓ బాధితురాలి కథ
- చైనా అరుణాచల్ ప్రదేశ్ను 'దక్షిణ టిబెట్' అని ఎందుకు అంటోంది
- కరోనావైరస్: వ్యాక్సీన్ తీసుకున్న తర్వాత ఆల్కహాల్ తాగొచ్చా?
- మనిషికి పంది కిడ్నీపెట్టిన వైద్యులు
- కరోనా వైరస్ సర్వే: మన శరీరంలో యాంటీబాడీస్ ఉంటే వైరస్ మళ్లీ సోకదా?
- భారత్- పాకిస్తాన్ క్రికెటర్లు ఆవేశంతో రెచ్చిపోయిన అయిదు సందర్భాలివే...
- కోవిడ్ వ్యాక్సినేషన్: వ్యాక్సీన్ తీసుకున్న తర్వాత కూడా కరోనావైరస్ సోకుతుందా?
- సిరియా: ఇస్లామిక్ స్టేట్ శిబిరాలలో చిన్నారుల జీవితాలు మగ్గిపోవాల్సిందేనా, అక్కడ కూడా మతాన్ని నూరిపోస్తున్నారా
- కరోనావైరస్: వ్యాక్సీన్లు తీసుకున్న తర్వాత దుష్ప్రభావాలు వస్తే ఏం చేయాలి?
(బీబీసీ తెలుగును ఫేస్బుక్, ఇన్స్టాగ్రామ్, ట్విటర్లో ఫాలో అవ్వండి. యూట్యూబ్లో సబ్స్క్రైబ్ చేయండి)




























